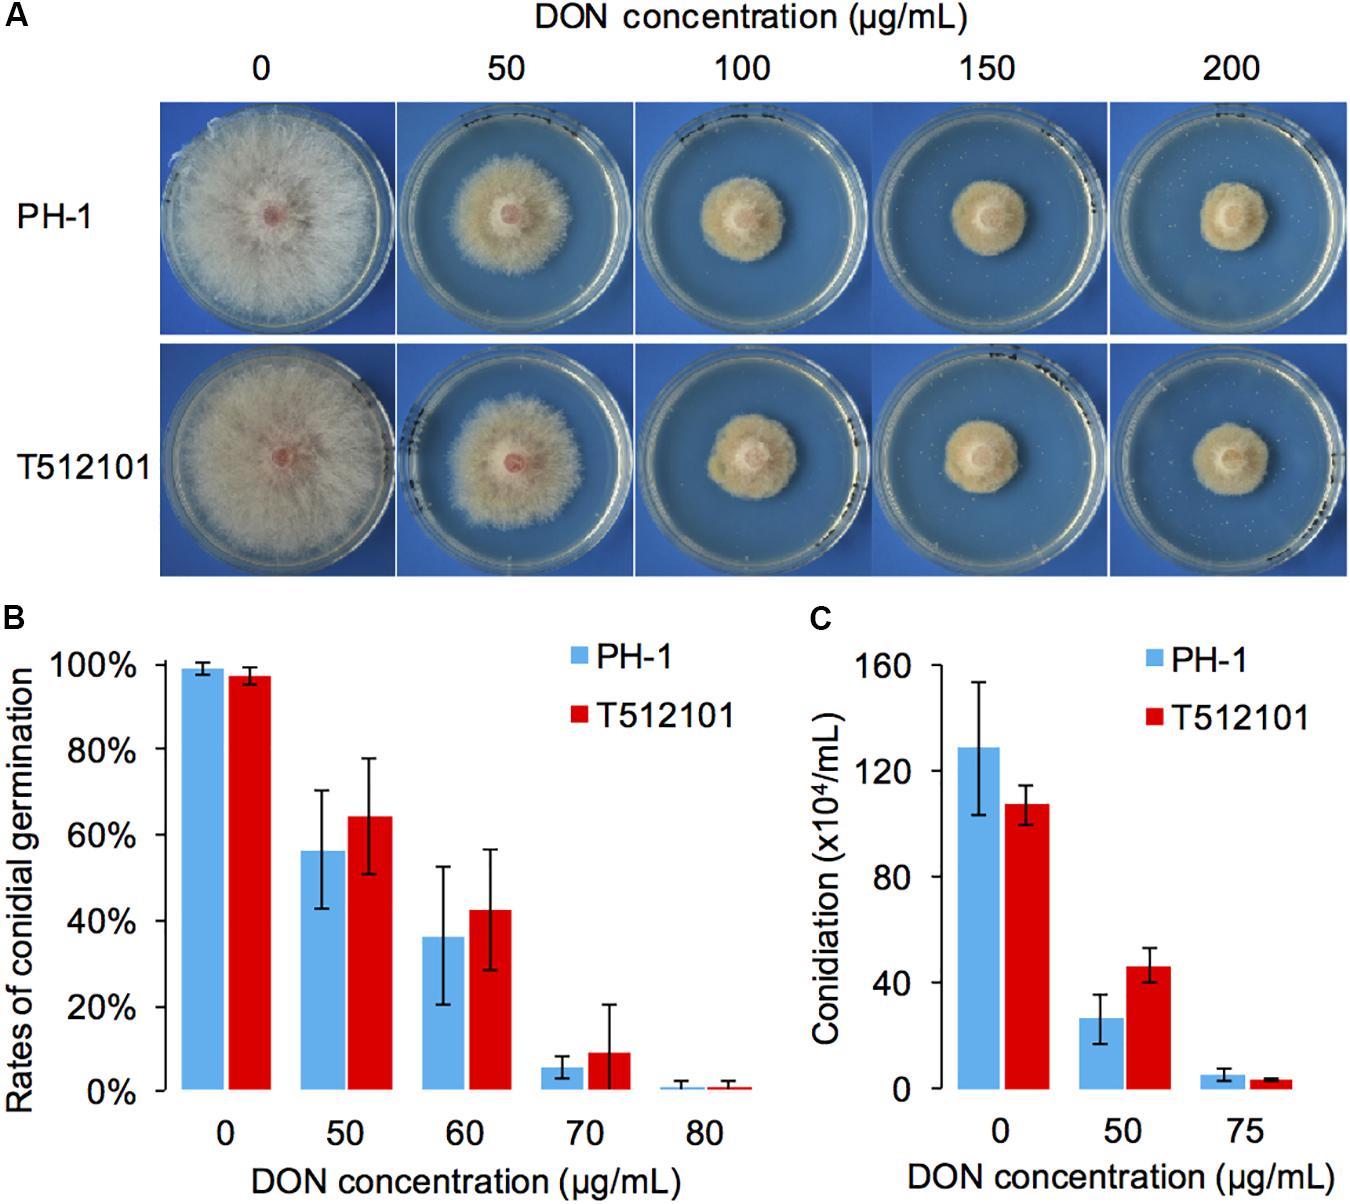

- 1State Key Laboratory of Crop Stress Biology for Arid Areas, College of Plant Protection, Northwest A&F University, Yangling, China
- 2Department of Botany and Plant Pathology, Purdue University, West Lafayette, IN, United States
- 3Innovation Experimental College, Northwest A&F University, Yangling, China
Trichothecene mycotoxins, such as deoxynivalenol (DON) produced by the fungal pathogen, Fusarium graminearum, are not only important for plant infection but are also harmful to human and animal health. Trichothecene targets the ribosomal protein Rpl3 that is conserved in eukaryotes. Hence, a self-defense mechanism must exist in DON-producing fungi. It is reported that TRI (trichothecene biosynthesis) 101 and TRI12 are two genes responsible for self-defense against trichothecene toxins in Fusarium. In this study, however, we found that simultaneous disruption of TRI101 and TRI12 has no obvious influence on DON resistance upon exogenous DON treatment in F. graminearum, suggesting that other mechanisms may be involved in self-defense. By using RNA-seq, we identified 253 genes specifically induced in DON-treated cultures compared with samples from cultures treated or untreated with cycloheximide, a commonly used inhibitor of eukaryotic protein synthesis. We found that transporter genes are significantly enriched in this group of DON-induced genes. Of those genes, 15 encode major facilitator superfamily transporters likely involved in mycotoxin efflux. Significantly, we found that genes involved in the metabolism of gamma-aminobutyric acid (GABA), a known inducer of DON production in F. graminearum, are significantly enriched among the DON-induced genes. The GABA biosynthesis gene PROLINE UTILIZATION 2-2 (PUT2-2) is downregulated, while GABA degradation genes are upregulated at least twofold upon treatment with DON, resulting in decreased levels of GABA. Taken together, our results suggest that transporters influencing DON efflux are important for self-defense and that GABA mediates the balance of DON production and self-defense in F. graminearum.
Introduction
Fusarium head blight caused by the fungal pathogen, Fusarium graminearum, is a devastating disease of wheat, maize, barley, and other grain cereals worldwide (Bai and Shaner, 2004; Goswami and Kistler, 2004). F. graminearum infects the spikelet of cereals and produces harmful mycotoxins during the infection. Thus, it not only causes severe yield losses but also contaminates the infected grains (Tanaka et al., 1988; Placinta et al., 1999). Deoxynivalenol (DON, formerly known as vomitoxin), a trichothecene mycotoxin, is the major secondary metabolite produced by F. graminearum and commonly detected in the cereal-based foods (Lombaert et al., 2003; Rasmussen et al., 2003; Tutelyan, 2004; Isebaert et al., 2005). DON severely impacts a number of critical cellular processes in both animals and plants, such as inhibition of protein synthesis, alteration of membrane structure, and inhibition of mitochondrial function (Rocha et al., 2005). It impairs the growth, immunity, and reproduction of human and animals (Pestka and Smolinski, 2005; Bimczok et al., 2007; Pestka, 2010; Sobrova et al., 2010). Besides, DON biosynthesis is important for the infection of host plants (Proctor et al., 1995, 1997), and the aggressiveness of F. graminearum is positively correlated with the capacity of DON production (Mesterházy, 2002).
TRI5, which encodes an enzyme that catalyzes the first step in the trichothecene biosynthetic pathway, was the first gene identified for trichothecene biosynthesis (Proctor et al., 1997; Brown et al., 2001). TRI5 is located in the core TRI gene cluster on chromosome 2, which represents the major cluster responsible for trichothecene biosynthesis. In the core TRI gene cluster, seven genes (TRI3, TRI4, TRI5, TRI7, TRI8, TRI11, and TRI13) encode the enzymes required for trichothecene biosynthesis. Two are regulator genes (TRI6 and TRI10), and one (TRI12) encodes a major facilitator superfamily (MFS) transporter (Brown et al., 2001; Alexander et al., 2009). Beyond the core TRI gene cluster, a mini-cluster formed by TRI1 and TRI16 on chromosome 1 and a single-gene of TRI101 on chromosome 4 are also required for trichothecene biosynthesis.
Trichothecene primarily targets ribosomal protein L3 (Rpl3), which is conserved in eukaryotes, and inhibits protein synthesis by interfering with elongation termination (Wei et al., 1974; Rocha et al., 2005). Thus, trichothecene is not only toxic to animals and plants but also harmful to the pathogen itself. A self-defense mechanism must exist in fungi. TRI101 and TRI12 have been shown to provide some degree of resistance to trichothecene (Kimura et al., 1998a,b; Alexander et al., 1999; McCormick et al., 1999). Tri101 acetylates trichothecene to a hypotoxic form by catalyzing the transfer of an O-acetyl group at the C3 position (Garvey et al., 2008). Yeast expressing FgTRI101 is resistant to the trichothecene T-2 toxin (Kimura et al., 1998a), and the expression of FgTRI101 is induced in T-2 toxin-treated mycelia of F. graminearum (Kimura et al., 1998b). Yeast expressing the TRI101 from Fusarium sporotrichioides has also increased tolerance to the trichothecene diacetoxyscirpenol (DAS) toxin (McCormick et al., 1999). Tri12 is an MFS transporter involved in DON efflux (Menke et al., 2012). In F. sporotrichioides, the TRI12 disruption mutant exhibits increased sensitivity to DAS (Alexander et al., 1999). In F. graminearum, a TRI12 disruption mutant was also shown to be sensitive to endogenous mycotoxin in a trichothecene biosynthesis induction (TBI) medium (Menke et al., 2012). Furthermore, transgenic plants carrying TRI101 have enhanced tolerance to exogenously added trichothecenes (Alexander, 2008).
Although TRI101 and TRI12 are involved in the trichothecene tolerance, they are not essential for self-defense. In F. sporotrichioides, the spore germination of the FsTRI12 disruption mutant is unaffected by exogenous DAS (Alexander et al., 1999), and the Fstri101 deletion mutant is only slightly reduced in radial growth at a high concentration of DAS or T-2 toxin (McCormick et al., 1999). In F. graminearum, the radial growth of FgTRI12 disruption mutant is only slightly reduced compared to the wild-type in TBI medium (Menke et al., 2012). Therefore, beyond TRI101 and TRI12, additional self-defense mechanism may exist in these fungi.
To facilitate the study of the self-defense mechanism in F. graminearum, in this study, we constructed a mutant simultaneously disrupted in TRI5, TRI12, and TRI101, and performed RNA-seq analysis of the mutant treated with exogenous DON. The objectives of our study were to determine: (i) whether simultaneous disruption of TRI12 and TRI101 results in destruction of DON resistance and (ii) whether additional genes or pathways are involved in the self-defense. We found that knocking out TRI12 and TRI101 has no obvious influence on the radial growth and conidial germination with or without exogenous DON treatment. By RNA-seq analysis, we found that transporters are important for DON resistance. Importantly, we found that gamma-aminobutyric acid (GABA) is involved in the self-defense and likely balances DON production and self-defense in F. graminearum.
Results
Knockout of TRI5–TRI12 and TRI101 Blocks DON Production and Plant Infection
Because TRI5 and TRI12 are separated by TRI10–TRI9–TRI11 in the core TRI gene cluster, the entire TRI5–TRI12 (TRI5–TRI10–TRI9–TRI11–TR12) cluster was replaced with the hygromycin phosphotransferase (HPT) gene (Supplementary Figure S1A) in F. graminearum strain PH-1, resulting in the tri5–tri12 mutant (strain T512). The TRI101 gene was subsequently replaced with the neomycin phosphotransferase II (NPT) gene in strain T512, and the resulting mutant is designated tri5–12–tri101 mutant (strain T512101) in this study (Supplementary Figure S1A). The disruptions of these regions were confirmed by Southern blot (Supplementary Figure S1B). In all of the two replacements, we could detect the inserted selection makers, but none of the targeted DNA fragments were detected (Supplementary Figure S1B). These data clearly confirmed that both targeted regions were successfully replaced.
The production of DON in tri5–12 and tri5–12–tri101 mutants on liquid TBI medium was measured. As expected, DON production in these two mutants was absolutely abolished (Figure 1A), which is consistent with the fact that TRI5 is essential for DON production in F. graminearum. To examine whether the disruption of TRI5–TRI12 and TRI101 affects infection of the host plant, we inoculated wheat spikelets with conidia produced by the mutants. Compared to the wild-type of F. graminearum strain PH-1, the pathogenicity of the mutants tri5–12 and tri5–12–tri101 was nearly lost (Figure 1B). By 2 weeks after inoculation, the disease lesions were restricted to the inoculation site and did not spread to the nearby spikelet (Figure 1B). These data confirmed that TRI5–TRI12 and TRI101 are critical for the pathogenicity of F. graminearum on wheat heads.

FIGURE 1. DON production and pathogenicity of the tri5–12 and tri5–12–tri101 mutants. (A) Boxplot of DON yields assayed on liquid TBI culture for F. graminearum strains PH-1, T512, and T512101. For each strain, five replicates were used. (B) Flowering wheat heads were drop-inoculated with conidia from the same set of strains. Spikelets with typical symptoms were photographed 14 days post-inoculation. The percentages of infected spikelets are indicated (mean ± SD).
The tri5–12–tri101 Mutant Is Not Hypersensitive to DON Treatment
Compared to the wild-type PH-1, the two mutants, tri5–12 and tri5–12–tri101, did not show any significant changes in radial growth (Supplementary Figure S2). To examine whether tri5–12–tri101 mutant has decreased resistance to DON, the radial growth of the mutant was analyzed in the presence of exogenous DON. Although adding increasing concentrations of DON inhibited the radial growth of the mutant, there was no obvious difference (IC50PH-1 = 45.1, IC50tri5-12-tri101 = 52.4) observed between the mutant and wild-type strain (Figure 2A). Consistently, the conidial germination of the mutant was inhibited at rates similar to those in the wild-type strain (IC50PH-1 = 56.7, IC50tri5-12-tri101 = 59.7) treated with different concentrations of exogenous DON (Figure 2B). Similar levels of conidiation inhibition were also observed between the DON-treated mutant and the wild-type (Figure 2C). These results suggest that the deletion of both TRI12 and TRI101 has no obvious effects on DON resistance in F. graminearum.
FIGURE 2. DON resistance assays of the tri5–12–tri101 mutant. (A) The radial growth of PH-1 and T512101 cultured on YPG medium containing 0, 50, 100, 150, and 200 μg/mL DON, respectively, at 25°C for 72 h. (B) Conidial germination of PH-1 and T512101 on YPD medium containing 0, 50, 60, 70, and 80 μg/mL DON, respectively. Error bars represent the SD of three replicates. (C) Conidiation of PH-1 and T512101 on CMC medium containing 0, 50, and 75 μg/mL DON, respectively. Error bars represent the SD of six replicates.
RNA-Seq Identification of Genes Specifically Induced by DON Treatment
To identify novel genes conferring self-defense, we next performed RNA-seq to analyze gene expression in the DON-treated or untreated (CK) tri5–12–tri101 mutant. Because DON inhibits protein synthesis, the expression of numerous genes not related to DON resistance may be affected. To identify the genes specifically induced by DON treatment, we used cycloheximide (CHX), a eukaryote protein synthesis inhibitor, as a control to filter out the differentially expressed genes from those caused by general inhibition of protein synthesis. For each treatment, three biological replicates were used, and each of the biological replicates contained two technical repeats. We calculated the distances of these 18 samples based on the biological coefficient of variation. As expected, all the samples from the same treatment could be grouped together (Figure 3A). Further clustering analysis based on the correlation relationships of these samples also suggested that the genes expressed in different treatments are distinct (Figure 3B). Therefore, DON treatment considerably affected the profile of tri5–12–tri101 gene expression.

FIGURE 3. RNA-seq analysis of the tri5–12–tri101 mutant. (A) Multidimensional scaling plot of the transcriptome profiles of the tri5–12–tri101 mutant treated with DON, CHX, or untreated (CK). (B) Hierarchical clustering analysis showing the relationship of the gene expression among different samples according to RNA-seq analysis. In (A) and (B), the untreated tri5–12–tri101 mutant, the mutant treated with DON, or CHX are marked in blue, red, or black, respectively. Each sample contains six replicates, including three biological replicates, and each biological replicate has two technical replicates. (C) Comparison of the differentially expressed genes in tri5–12–tri101 mutant treated with DON or CHX. The genes upregulated in DON (in red) and CHX (in green) treatments, and the genes downregulated in DON (in blue) and CHX (in orange) treatments are illustrated in the Venn diagram. Up arrows indicate upregulation, while the down arrows indicate downregulation. (D) Heatmap showing the expression patterns of the 253 specifically induced genes in the tri5–12–tri101 mutant upon DON treatment. Genes in class I (in red) are upregulated upon DON treatment. Genes in class II (in blue) are upregulated upon DON treatment, but downregulated upon CHX treatment.
Compared to the CK, 706 and 1,542 genes were upregulated and downregulated, respectively, at least twofold upon DON treatment of the tri5–12–tri101 mutant, while 2,135 and 2,818 genes were upregulated and downregulated upon CHX treatment (Figure 3C). In total, 253 upregulated (Supplementary Table S1) and 375 downregulated genes were specifically affected by DON treatment (Figure 3C). Notably, 37 of these 253 DON-specific induced genes were downregulated even in the CHX samples (Figures 3C,D). These specifically induced genes likely confer tolerance and self-defense against DON.
DON-Specific Induced Genes Are Enriched for Transporter Genes
To identify which types of genes mainly contribute to the tolerance against DON in the mutant, we performed functional annotation on the specifically induced genes resulting from DON treatment. Interestingly, 17 and 26 genes encoding different types of transporters were found by BLAST and gene ontology (GO) analyses, respectively (Supplementary Table S1). Further statistical analysis revealed that the transporter genes were significantly enriched among these specifically induced genes (Figures 4A,B). To obtain a comprehensive understanding of the induced transporter genes, we performed formal transporter annotation. In total, we found that 13% (33 of the 253) of the specifically induced genes were transporter genes (Supplementary Table S2), which is 2.5-fold higher than the ratio of the transporter genes in the genome of F. graminearum.

FIGURE 4. Transporter genes are enriched in DON-specific induced genes. (A) The percentages of genes involved in “transmembrane transport” processes or have “transmembrane transporter activity” in the 253 DON-specific induced genes (Induced) or in the total genes (All) according to GO annotation. (B) The percentages of genes annotated as a transporter in the 253 DON-specific induced genes (Induced) or in the total genes (All) according to BLAST annotation. In (A) and (B), P-values were obtained from chi-square tests. (C) Classification of 33 specifically induced transporter genes. Fifteen MFS transporter genes and two APC transporter genes are highlighted in red and pink, respectively. Each blue stripe in the circle represents one transporter gene of other families as listed in Supplementary Table S2. (D) Percentage of the transporter genes with designated substrates.
The MFS Transporters May Be Important for Self-Defense
Notably, among these 33 transporters, 15 of them were MFS transporters, two of them were amino acid–polyamine–organocation (APC) family transporters, and the rest 16 belonged to different transporter families (Figure 4C). Tri12 is a known MFS family transporter that exports trichothecene in Fusarium (Alexander et al., 1999; Menke et al., 2012). Therefore, it is quite likely that these transporters, or at least some of the MFS family transporters, have a role in pumping out DON and thus reducing the intracellular DON level. Consistently, the homolog of FGRRES_01997 (Supplementary Table S2), which encodes an MFS transporter MgMfs1, is shown to have a role in resistance to toxic compounds and fungicides in Zymoseptoria tritici (Roohparvar et al., 2007). A homolog of FGRRES_03033 (Supplementary Table S2), which encodes an MFS transporter Ctb4 in Cercospora nicotianae, is required for export of the toxin, cercosporin, and fungal virulence (Choquer et al., 2007). Both these two MFS transporters (FGRRES_01997 and FGRRES_03033) were strongly induced upon various concentrations of DON treatments in F. graminearum, as revealed by quantitative real time polymerase chain reaction (qRT-PCR) assays (Supplementary Figure S3). In addition, we found that most of the substrate profiles of these transporters were similar to that of the Tri12 transporter (Figure 4D and Supplementary Table S2). Taken together, we conclude that the MFS transporters are important for self-defense against DON in F. graminearum.
DON-Specific Induced Genes Are Enriched in Genes Involved in GABA Metabolism
To identify which processes mainly contribute to the self-defense in the mutant, we performed GO enrichment analysis of the 253 DON-specific induced genes. Interestingly, only two enriched GO terms were found (Table 1). The most significant GO term was GABA metabolic process, and the other significant GO term was reactive nitrogen species (RNS) metabolic process. Close examination showed that five (Table 2) of the seven genes involved in GABA metabolism and three of the six genes involved in RNS metabolism were specifically upregulated upon DON treatment (Table 1). These results suggest that the GABA and RNS metabolic pathways or related genes may contribute to the tolerance and self-defense against DON mycotoxin.
Reduction of GABA Accumulation as a Mechanism for Self-Defense
Gamma-aminobutyric acid is a major inhibitory neurotransmitter in animals and also an important signaling metabolite produced by plants and fungi (Kumar and Punekar, 1997; Gilliham and Tyerman, 2016). The GABA pathway is present in fungi (Kumar and Punekar, 1997), and GABA is associated with the DON production in F. graminearum (Bonnighausen et al., 2015). The GABA shunt bypasses the citric acid cycle from alpha-ketoglutaric acid to succinic acid via glutamate, GABA, and succinic semialdehyde (SSA; Figure 5). In addition, GABA synthesis is induced by agmatine (Lowe et al., 2010; Suzuki et al., 2013), putrescine, and 4-aminobutyraldehyde (Shelp et al., 2012). Further, agmatine (Suzuki et al., 2013), putrescine (Gardiner et al., 2010), and GABA (Bonnighausen et al., 2015) are all positively associated with DON production in F. graminearum (Figure 5).

FIGURE 5. GABA consumption confers self-defense in F. graminearum. GABA shunt (middle) bypasses the citric acid cycle (left). In the GABA shunt, glutamate is metabolized to GABA. Various nitrogen substrates, such as agmatine, putrescine, and 4-aminobutyralehyde result in GABA accumulation (right). Furthermore, agmatine (1), putrescine (2), and GABA (3) induce DON production (in orange). In the tri5–12–tri101 mutant, the GABA biosynthesis gene PUT2-2 is downregulated, while the GABA degradation genes, GTAs and SSADHs, are upregulated upon DON treatment, which results in a decrease in GABA. The gene name in red, blue, and green indicates the gene is upregulated, unchanged, and downregulated, respectively, according the RNA-seq data. Barplots represent the relative expression levels obtained by qRT-PCR in DON treated (blue) and untreated (black) mycelia.
To investigate how GABA may contribute to the self-defense, we examined the expression of the GABA metabolic genes in the tri5–12–tri101 mutant upon DON treatment according to our RNA-seq data. Interestingly, we found that the two GTA genes, which encode GABA transaminases that catalyze GABA to SSA, were upregulated (Figure 5). In addition, expression of all of the three SSADH genes, which encode SSA dehydrogenase that further catalyze SSA to succinic acid, was also upregulated (Figure 5). However, the expression of two genes, GLUTAMATE DECARBOXYLASE (GAD) and PROLINE UTILIZATION 2-1 (PUT2-1), which contribute to GABA accumulation, was unchanged (Figure 5). PROLINE UTILIZATION 2-2 (PUT2-2) was even downregulated in the mutant upon DON treatment (Figure 5). The expression of PUT2, GTA, and SSADH genes was further confirmed by qRT-PCR analysis (barplots in Figure 5); all of them are consistent with the RNA-seq result.
To confirm the reduction of the GABA accumulation upon DON treatment, we performed high-performance liquid chromatography (HPLC) analysis in the tri5–12–tri101 mutant. Compared to the untreated mycelia, the level of GABA accumulation in the mutant was significantly reduced (Figure 6). Similar results were obtained by using the wild-type strain PH-1 (Figure 6). Taken together, it is most likely that F. graminearum prevents DON accumulation by reducing GABA accumulation.

FIGURE 6. Relative accumulation level of GABA in F. graminearum. The level of GABA was normalized to the untreated mycelia (0 μg/mL). Error bars represent the SD of three technical replicates. One-sided t-tests were used to access the significances between DON treated and untreated samples, “∗” stands for P-value < 0.05, and “∗∗” stands for P-value < 0.01.
Discussion
Trichothecene is not only toxic to animals and plants but also harmful to the pathogen itself. Therefore, DON-producing fungi must possess a protective self-defense mechanism. TRI101 and TRI12 are two self-defense genes for mycotoxin reported in Fusarium (Figure 7): Tri101 acetylates trichothecene to a hypotoxic form (Kimura et al., 1998a; Garvey et al., 2008), and Tri12 pumps trichothecene to the extracellular zone of the cells (Alexander et al., 1999; Menke et al., 2012). In this study, we investigated whether simultaneous disruption of TRI12 and TRI101 could result in severe impairment of DON resistance in F. graminearum. Unexpectedly, our results suggested that the tri5–12–tri101 mutant was not hypersensitive to exogenous DON treatment compared to wild-type PH-1. In fact, previous studies showed that TRI12 or TRI101 knockout mutants are not significantly impaired in toxin resistance (Alexander et al., 1999; McCormick et al., 1999; Menke et al., 2012). In addition, previous self-defense assays for TRI101 were conducted in F. sporotrichioides or yeast, and used T-2 or DAS, but not DON toxin treatment (Kimura et al., 1998a; McCormick et al., 1999). The self-defense role for TRI12 in F. graminearum was analyzed on TBI medium, rather than by treatment with exogenous DON (Menke et al., 2012). It is possible that one or two other genes may play a minor role in the self-protection against mycotoxin in F. graminearum. By using the tri5–12–tri101 mutant, we identified 253 genes specifically induced upon DON treatment relative to CHX treatment. The transporter genes and GABA metabolism genes are enriched among these DON-specific induced genes, suggesting that they are most likely involved in the establishment of DON resistance for F. graminearum.

FIGURE 7. Proposed model for the self-defense mechanism in F. graminearum. (1) Tri101, which acetylates DON into a hypotoxic form, is shown to contribute to self-defense. (2) Many MFS transporters, including Tri12, are likely to export intracellular DON. (3) GABA mediates DON production and self-defense in F. graminearum. In most cases, increasing GABA accumulation will result in increasing DON production (red line). However, higher concentrations of intracellular DON may feedback inhibit DON production by reducing GABA accumulation (green line). It suppresses the expression of GABA biosynthesis gene PUT2-2 and induces the expression of GABA degradation genes GTA and SSADH, preventing further DON accumulation.
Transporters provide a channel for drug and mycotoxin efflux. Indeed, Tri12 is an MFS transporter (Menke et al., 2012). Many MFS transporters and ATP-binding cassette (ABC) transporters have been shown to contribute to toxin efflux in fungi (Coleman and Mylonakis, 2009). In this study, 33 transporters were identified in the DON-specific induced genes. Of those, two were homologous to toxin-efflux-related MFS transporters Cbt4 and MgMfs1, respectively. Many transporter genes were also identified in a trichodiene (the chemical product of Tri5)-treated TRI5 deletion mutant (Seong et al., 2009). Therefore, transporters, especially MFS transporters, likely cooperate and collectively contribute to DON resistance (Figure 7).
Intriguingly, we found that GABA also likely contributes to self-defense in F. graminearum (Figure 7). It has been shown that GABA positively regulates DON production (Bonnighausen et al., 2015). For example, metabolome analysis of Fusarium in both toxin-producing and in non-producing conditions revealed that the concentration of GABA is elevated in the DON-inducing medium (Lowe et al., 2010). Adding of GABA to culture medium strongly induces DON biosynthesis in F. graminearum (Bonnighausen et al., 2015). In Fusarium asiaticum, addition of GABA inducible agmatine to the culture medium also resulted in significantly high levels of DON production (Suzuki et al., 2013). In this study, however, we found that the GTA genes that metabolize GABA are upregulated, and PUT2-2 that leads to GABA accumulation is downregulated in the DON-treated tri5–12–tri101 mutant. Hence, the convergent behaviors of these genes reduce the intracellular level of GABA (Figure 7). It seems logical to conclude that DON production and self-defense are balanced by GABA (Figure 7). Generally, GABA triggers DON production, but when DON accumulates at a higher level, the fungi may protect themselves by preventing GABA accumulation thereby reducing DON accumulation (Figure 7). Besides, the upregulation of the transporter genes and reduction of GABA level upon DON treatment in F. graminearum may tightly linked together. In plant, it is shown that GABA negatively regulates the activity of plant-specific anion transporters (Ramesh et al., 2015). It is also possible that, in addition to preventing/switch-off DON accumulation, GABA metabolism dynamics may also be related to the upregulation of the transporter to pump out the mycotoxin when DON accumulates at a higher level.
Materials and Methods
Strains and Culture Conditions
Fusarium graminearum (Gibberella zeae) strain PH-1 and mutant strains T512 and T512101 were cultured on potato dextrose agar (PDA) medium at 25°C. For radial growth determinations, strains were cultured on PDA, complete minimal (CM), or YPG (0.3% yeast extract, 1% peptone, and 2% glucose) medium at 25°C for 72 h. Conidial germination rates were determined on YPD (1% yeast extract, 2% peptone, and 2% dextrose) medium at 25°C for 8 h. Conidiation was assayed on 5-day-old carboxymethylcellulose (CMC) cultures.
Generation of the tri5–12–tri101 Deletion Mutant
The deletion mutants were prepared by the split-marker method as described previously (Catlett et al., 2002). Briefly, to generate the tri5–12 mutant, the upstream and downstream flanking sequences were amplified from genomic DNA, and fused with the HPT gene by overlapping polymerase chain reaction (PCR). The fusion constructs were transformed into protoplasts of PH-1 by the method described previously (Zhou et al., 2011). The generation of the tri5–12–tri101 mutant was similar to procedures used for the tri5–12 mutant, except that the target gene was replaced by the NPT gene, and strain T512 was used for transformation. The putative knockout mutants were screened by PCR and further verified by Southern blot hybridizations.
Plant Infection and DON Production Assays
Conidia harvested from 5-day-old CMC cultures were resuspended in sterile distilled water to a final concentration of 1.0–1.5 × 105 spores/mL as described previously (Jiang et al., 2016). The flowering wheat heads of wheat cultivar Norm were drop-inoculated with 10 μL of conidial suspensions as described previously (Jiang et al., 2016). DON production in liquid TBI cultures was assayed as described previously (Jiang et al., 2016).
CHX and DON Treatments of the tri5–12–tri101 Mutant
The conidia of the tri5–12–tri101 mutant were harvested from 5-day-old CMC medium and shaken in liquid CM medium at 25°C for 72 h. The germinated conidia were then collected and transferred to the liquid CM medium with 75 μg/mL DON or 10 μg/mL CHX, respectively. After 5-day shaking, the freshly developed mycelia were collected for RNA-seq analysis. Notably, upon treatment with 75 μg/mL DON or 10 μg/mL CHX treatment, the germination of the conidia was nearly 100% inhibited in F. graminearum strain PH-1.
RNA-Seq Analysis
Total RNAs isolated from the DON-treated, CHX-treated, and untreated (CK) mycelia were sequenced with an Illumina HiSeq 2500 at Shanghai Biotechnology Corporation. For each sample, three biological replicates with two technical replicates were sequenced. RNA-seq data were deposited in the NCBI SRA database under accession number SRP120765. The clean data were mapped to the genome of F. graminearum (King et al., 2015) by using hisat2 (Kim et al., 2015) with default parameters. The differentially expressed genes (log2FC > 1 and FDR < 0.05) were carried out based on the read counts by edgeRun with TMM normalization (Dimont et al., 2015) as described previously (Wang et al., 2017). GO annotation was carried out with Blast2GO (Conesa and Gotz, 2008), and GO enrichment analysis was performed by the parent–child union method with Benjamini–Hochberg correction as developed in Ontologizer (Bauer et al., 2008).
Transporter Annotation
To identify the transporter genes in DON-specific induced genes, a BLAST search (E-value < 1e-10) was first performed against the curated transporter classification database (Saier et al., 2016). To remove the false positive predictions, the candidate transporters and their potential substrates were further examined by the AAindex and PSSM-based methods as developed in TrSSP (Mishra et al., 2014).
qRT-PCR Analysis
The qRT-PCR was performed as previously described (Wang et al., 2016); 1 μg of total RNA was treated with DNase I and subjected to the first strand cDNA synthesis. Since the expression of the commonly used reference gene GzUBH and BTUB is changed upon DON treatment, FGRRES_00746 was selected as a reference gene according to the RNA-seq data generated in this study. All the primers used for qRT-PCR analysis are listed in Supplementary Table S3.
HPLC Analysis of GABA
High-performance liquid chromatography analysis of GABA in mycelia was performed as previously described (Bonnighausen et al., 2015). In brief, GABA was extracted by water/chloroform/methanol (3:5:12, v/v/v) from mycelia, the derivatization was performed with o-phthalaldehyde (OPA), and the OPA derivatized samples were detected at 338 nm.
Author Contributions
HL, J-RX, and QW conceived and designed the experiments. DC, MW, JZ, and QW performed the experiments. QW and HL analyzed the data. QW wrote the manuscript. HL and CJ improved the manuscript.
Funding
This study was supported by the National Natural Science Foundation of China (No. 31201464) and China Postdoctoral Science Foundation (No. 2015M580884).
Conflict of Interest Statement
The authors declare that the research was conducted in the absence of any commercial or financial relationships that could be construed as a potential conflict of interest.
Acknowledgments
We thank Dr. Larry Dunkle at Purdue University for language editing the manuscript, Chunlan Wu for the excellent technical support, and Dr. Chenfang Wang for the insightful discussions.
Supplementary Material
The Supplementary Material for this article can be found online at: https://www.frontiersin.org/articles/10.3389/fpls.2018.00438/full#supplementary-material
References
Alexander, N. J. (2008). The TRI101 story: engineering wheat and barley to resist Fusarium head blight. World Mycotoxin J. 1, 31–37. doi: 10.3920/WMJ2008.x004
Alexander, N. J., Mccormick, S. P., and Hohn, T. M. (1999). TRI12, a trichothecene efflux pump from Fusarium sporotrichioides: gene isolation and expression in yeast. Mol. Gen. Genet. 261, 977–984. doi: 10.1007/s004380051046
Alexander, N. J., Proctor, R. H., and Mccormick, S. P. (2009). Genes, gene clusters, and biosynthesis of trichothecenes and fumonisins in Fusarium. Toxin Rev. 28, 198–215. doi: 10.1080/15569540903092142
Bai, G., and Shaner, G. (2004). Management and resistance in wheat and barley to Fusarium head blight. Annu. Rev. Phytopathol. 42, 135–161. doi: 10.1146/annurev.phyto.42.040803.140340
Bauer, S., Grossmann, S., Vingron, M., and Robinson, P. N. (2008). Ontologizer 2.0 - a multifunctional tool for GO term enrichment analysis and data exploration. Bioinformatics 24, 1650–1651. doi: 10.1093/bioinformatics/btn250
Bimczok, D., Doll, S., Rau, H., Goyarts, T., Wundrack, N., Naumann, M., et al. (2007). The Fusarium toxin deoxynivalenol disrupts phenotype and function of monocyte-derived dendritic cells in vivo and in vitro. Immunobiology 212, 655–666. doi: 10.1016/j.imbio.2007.05.002
Bonnighausen, J., Gebhard, D., Kroger, C., Hadeler, B., Tumforde, T., Lieberei, R., et al. (2015). Disruption of the GABA shunt affects mitochondrial respiration and virulence in the cereal pathogen Fusarium graminearum. Mol. Microbiol. 98, 1115–1132. doi: 10.1111/mmi.13203
Brown, D. W., Mccormick, S. P., Alexander, N. J., Proctor, R. H., and Desjardins, A. E. (2001). A genetic and biochemical approach to study trichothecene diversity in Fusarium sporotrichioides and Fusarium graminearum. Fungal Genet. Biol. 32, 121–133. doi: 10.1006/fgbi.2001.1256
Catlett, N. L., Lee, B.-N., Yoder, O. C., and Turgeon, B. G. (2002). Split-marker recombination for efficient targeted deletion of fungal genes. Fungal Genet. News 50, 9–11. doi: 10.1007/s00294-010-0294-2
Choquer, M., Lee, M. H., Bau, H. J., and Chung, K. R. (2007). Deletion of a MFS transporter-like gene in Cercospora nicotianae reduces cercosporin toxin accumulation and fungal virulence. FEBS Lett. 581, 489–494. doi: 10.1016/j.febslet.2007.01.011
Coleman, J. J., and Mylonakis, E. (2009). Efflux in fungi: la piece de resistance. PLoS Pathog. 5:e1000486. doi: 10.1371/journal.ppat.1000486
Conesa, A., and Gotz, S. (2008). Blast2GO: a comprehensive suite for functional analysis in plant genomics. Int. J. Plant Genomics 2008:619832. doi: 10.1155/2008/619832
Dimont, E., Shi, J., Kirchner, R., and Hide, W. (2015). edgeRun: an R package for sensitive, functionally relevant differential expression discovery using an unconditional exact test. Bioinformatics 31, 2589–2590. doi: 10.1093/bioinformatics/btv209
Gardiner, D. M., Kazan, K., Praud, S., Torney, F. J., Rusu, A., and Manners, J. M. (2010). Early activation of wheat polyamine biosynthesis during Fusarium head blight implicates putrescine as an inducer of trichothecene mycotoxin production. BMC Plant Biol. 10:289. doi: 10.1186/1471-2229-10-289
Garvey, G. S., Mccormick, S. P., and Rayment, I. (2008). Structural and functional characterization of the TRI101 trichothecene 3-O-acetyltransferase from Fusarium sporotrichioides and Fusarium graminearum: kinetic insights to combating Fusarium head blight. J. Biol. Chem. 283, 1660–1669. doi: 10.1074/jbc.M705752200
Gilliham, M., and Tyerman, S. D. (2016). Linking metabolism to membrane signaling: the GABA-malate connection. Trends Plant Sci. 21, 295–301. doi: 10.1016/j.tplants.2015.11.011
Goswami, R. S., and Kistler, H. C. (2004). Heading for disaster: Fusarium graminearum on cereal crops. Mol. Plant Pathol. 5, 515–525. doi: 10.1111/j.1364-3703.2004.00252.x
Isebaert, S., Haesaert, G., Devreese, R., Maene, P., Fremaut, F., and Vlaemynck, G. (2005). Fusarium spp. and Fusarium mycotoxins in maize: a problem for Flanders? Commun. Agric. Appl. Biol. Sci. 70, 129–136.
Jiang, C., Zhang, C., Wu, C., Sun, P., Hou, R., Liu, H., et al. (2016). TRI6 and TRI10 play different roles in the regulation of deoxynivalenol (DON) production by cAMP signalling in Fusarium graminearum. Environ. Microbiol. 18, 3689–3701. doi: 10.1111/1462-2920.13279
Kim, D., Langmead, B., and Salzberg, S. L. (2015). HISAT: a fast spliced aligner with low memory requirements. Nat. Methods 12, 357–360. doi: 10.1038/nmeth.3317
Kimura, M., Kaneko, I., Komiyama, M., Takatsuki, A., Koshino, H., Yoneyama, K., et al. (1998a). Trichothecene 3-O-acetyltransferase protects both the producing organism and transformed yeast from related mycotoxins. Cloning and characterization of Tri101. J. Biol. Chem. 273, 1654–1661. doi: 10.1074/jbc.273.3.1654
Kimura, M., Shingu, Y., Yoneyama, K., and Yamaguchi, I. (1998b). Features of Tri101, the trichothecene 3-O-acetyltransferase gene, related to the self-defense mechanism in Fusarium graminearum. Biosci. Biotechnol. Biochem. 62, 1033–1036. doi: 10.1271/bbb.62.1033
King, R., Urban, M., Hammond-Kosack, M. C., Hassani-Pak, K., and Hammond-Kosack, K. E. (2015). The completed genome sequence of the pathogenic ascomycete fungus Fusarium graminearum. BMC Genomics 16:544. doi: 10.1186/s12864-015-1756-1
Kumar, S., and Punekar, N. S. (1997). The metabolism of 4-aminobutyrate (GABA) in fungi. Mycol. Res. 101, 403–409. doi: 10.1017/S0953756296002742
Lombaert, G. A., Pellaers, P., Roscoe, V., Mankotia, M., Neil, R., and Scott, P. M. (2003). Mycotoxins in infant cereal foods from the Canadian retail market. Food Addit. Contam. 20, 494–504. doi: 10.1080/0265203031000094645
Lowe, R. G., Allwood, J. W., Galster, A. M., Urban, M., Daudi, A., Canning, G., et al. (2010). A combined 1H nuclear magnetic resonance and electrospray ionization-mass spectrometry analysis to understand the basal metabolism of plant-pathogenic Fusarium spp. Mol. Plant Microbe Interact. 23, 1605–1618. doi: 10.1094/MPMI-04-10-0092
McCormick, S. P., Alexander, N. J., Trapp, S. E., and Hohn, T. M. (1999). Disruption of TRI101, the gene encoding trichothecene 3-O-acetyltransferase, from Fusarium sporotrichioides. Appl. Environ. Microbiol. 65, 5252–5256.
Menke, J., Dong, Y., and Kistler, H. C. (2012). Fusarium graminearum Tri12p influences virulence to wheat and trichothecene accumulation. Mol. Plant Microbe Interact. 25, 1408–1418. doi: 10.1094/MPMI-04-12-0081-R
Mesterházy, Á. (2002). Role of deoxynivalenol in aggressiveness of Fusarium graminearum and F. culmorum and in resistance to Fusarium head blight. Eur. J. Plant Pathol. 108, 675–684. doi: 10.1023/A:1020631114063
Mishra, N. K., Chang, J., and Zhao, P. X. (2014). Prediction of membrane transport proteins and their substrate specificities using primary sequence information. PLoS One 9:e100278. doi: 10.1371/journal.pone.0100278
Pestka, J. J. (2010). Deoxynivalenol: mechanisms of action, human exposure, and toxicological relevance. Arch. Toxicol. 84, 663–679. doi: 10.1007/s00204-010-0579-8
Pestka, J. J., and Smolinski, A. T. (2005). Deoxynivalenol: toxicology and potential effects on humans. J. Toxicol. Environ. Health B Crit. Rev. 8, 39–69. doi: 10.1080/10937400590889458
Placinta, C. M., D’mello, J. P. F., and Macdonald, A. M. C. (1999). A review of worldwide contamination of cereal grains and animal feed with Fusarium mycotoxins. Anim. Feed Sci. Technol. 78, 21–37. doi: 10.1016/S0377-8401(98)00278-8
Proctor, R. H., Hohn, T. M., and Mccormick, S. P. (1995). Reduced virulence of Gibberella zeae caused by disruption of a trichothecene toxin biosynthetic gene. Mol. Plant Microbe Interact. 8, 593–601. doi: 10.1094/MPMI-8-0593
Proctor, R. H., Hohn, T. M., and Mccormick, S. P. (1997). Restoration of wild-type virulence to Tri5 disruption mutants of Gibberella zeae via gene reversion and mutant complementation. Microbiology 143(Pt 8), 2583–2591. doi: 10.1099/00221287-143-8-2583
Ramesh, S. A., Tyerman, S. D., Xu, B., Bose, J., Kaur, S., Conn, V., et al. (2015). GABA signalling modulates plant growth by directly regulating the activity of plant-specific anion transporters. Nat. Commun. 6:7879. doi: 10.1038/ncomms8879
Rasmussen, P. H., Ghorbani, F., and Berg, T. (2003). Deoxynivalenol and other Fusarium toxins in wheat and rye flours on the Danish market. Food Addit. Contam. 20, 396–404. doi: 10.1080/0265203031000082495
Rocha, O., Ansari, K., and Doohan, F. M. (2005). Effects of trichothecene mycotoxins on eukaryotic cells: a review. Food Addit. Contam. 22, 369–378. doi: 10.1080/02652030500058403
Roohparvar, R., De Waard, M. A., Kema, G. H., and Zwiers, L. H. (2007). MgMfs1, a major facilitator superfamily transporter from the fungal wheat pathogen Mycosphaerella graminicola, is a strong protectant against natural toxic compounds and fungicides. Fungal Genet. Biol. 44, 378–388. doi: 10.1016/j.fgb.2006.09.007
Saier, M. H. Jr., Reddy, V. S., Tsu, B. V., Ahmed, M. S., Li, C., and Moreno-Hagelsieb, G. (2016). The transporter classification database (TCDB): recent advances. Nucleic Acids Res. 44, D372–D379. doi: 10.1093/nar/gkv1103
Seong, K. Y., Pasquali, M., Zhou, X., Song, J., Hilburn, K., Mccormick, S., et al. (2009). Global gene regulation by Fusarium transcription factors Tri6 and Tri10 reveals adaptations for toxin biosynthesis. Mol. Microbiol. 72, 354–367. doi: 10.1111/j.1365-2958.2009.06649.x
Shelp, B. J., Bozzo, G. G., Trobacher, C. P., Zarei, A., Deyman, K. L., and Brikis, C. J. (2012). Hypothesis/review: contribution of putrescine to 4-aminobutyrate (GABA) production in response to abiotic stress. Plant Sci. 193–194, 130–135. doi: 10.1016/j.plantsci.2012.06.001
Sobrova, P., Adam, V., Vasatkova, A., Beklova, M., Zeman, L., and Kizek, R. (2010). Deoxynivalenol and its toxicity. Interdiscip. Toxicol. 3, 94–99. doi: 10.2478/v10102-010-0019-x
Suzuki, T., Kim, Y. K., Yoshioka, H., and Iwahashi, Y. (2013). Regulation of metabolic products and gene expression in Fusarium asiaticum by agmatine addition. Mycotoxin Res. 29, 103–111. doi: 10.1007/s12550-013-0158-y
Tanaka, T., Hasegawa, A., Yamamoto, S., Lee, U. S., Sugiura, Y., and Ueno, Y. (1988). Worldwide contamination of cereals by the Fusarium mycotoxins nivalenol, deoxynivalenol, and zearalenone. 1. Survey of 19 countries. J. Agric. Food Chem. 36, 979–983. doi: 10.1021/jf00083a019
Tutelyan, V. A. (2004). Deoxynivalenol in cereals in Russia. Toxicol. Lett. 153, 173–179. doi: 10.1016/j.toxlet.2004.04.042
Wang, Q., Jiang, C., Wang, C., Chen, C., Xu, J. R., and Liu, H. (2017). Characterization of the two-speed subgenomes of Fusarium graminearum reveals the fast-speed subgenome specialized for adaption and infection. Front. Plant Sci. 8:140. doi: 10.3389/fpls.2017.00140
Wang, Q., Li, T., Xu, K., Zhang, W., Wang, X., Quan, J., et al. (2016). The tRNA-derived small RNAs regulate gene expression through triggering sequence-specific degradation of target transcripts in the oomycete pathogen Phytophthora sojae. Front. Plant Sci. 7:1938. doi: 10.3389/fpls.2016.01938
Wei, C. M., Campbell, I. M., Mclaughlin, C. S., and Vaughan, M. H. (1974). Letter: binding of trichodermin to mammalian ribosomes and its inhibition by other 12,13-epoxytrichothecenes. Mol. Cell. Biochem. 3, 215–219. doi: 10.1007/BF01686646
Keywords: Fusarium head blight, Fusarium graminearum, DON resistance, MFS transporter, gamma-aminobutyric acid
Citation: Wang Q, Chen D, Wu M, Zhu J, Jiang C, Xu J-R and Liu H (2018) MFS Transporters and GABA Metabolism Are Involved in the Self-Defense Against DON in Fusarium graminearum. Front. Plant Sci. 9:438. doi: 10.3389/fpls.2018.00438
Received: 30 November 2017; Accepted: 21 March 2018;
Published: 13 April 2018.
Edited by:
Brigitte Mauch-Mani, University of Neuchâtel, SwitzerlandReviewed by:
Javier Plasencia, Universidad Nacional Autónoma de México, MexicoMostafa Abdelwahed Abdelrahman, Tohoku University, Japan
Copyright © 2018 Wang, Chen, Wu, Zhu, Jiang, Xu and Liu. This is an open-access article distributed under the terms of the Creative Commons Attribution License (CC BY). The use, distribution or reproduction in other forums is permitted, provided the original author(s) and the copyright owner are credited and that the original publication in this journal is cited, in accordance with accepted academic practice. No use, distribution or reproduction is permitted which does not comply with these terms.
*Correspondence: Huiquan Liu, bGl1aHVpcXVhbkBud3N1YWYuZWR1LmNu
†These authors have contributed equally to this work.